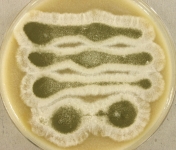
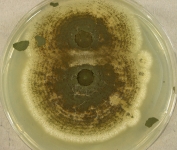

<< back to search
IMAGES:

Search Details
add to cart
| UAMH Number: | 11138 |
|---|---|
| Species Name: | Metarhizium anisopliae |
| Type: | |
| Synonyms: | Beauveria paranaensis / Beauveria paranensis / Entomophthora anisopliae / Isaria anisopliae / Isaria anisopliae var. americana / Isaria destructor / Metarhizium anisopliae var. anisopliae / Metarhizium cicadinum / Monocillium exsolum / Myrothecium commune / Oospora destructor / Paecilomyces paranaensis / Paecilomyces paranensis / Penicillium anisopliae / Penicillium cicadinum / Sporotrichum paranaense / Sporotrichum paranense |
| Taxonomy: | FUNGI Ascomycota, Sordariomycetes, Hypocreales, Clavicipitaceae |
| Strain History: | Conley, K. (N09-353) -> UAMH |
| Substrate: | fungal pneumonia in leucistic (albino) American alligator (Alligator mississippiensis); histopathology + for hyphae and conidia in palisades + oxalic acid crystals | Location: | USA Florida, Gainesville, University of Florida Veterinary Medical Center (GEO: 29.633,-82.35) |
| Isolator: | K. Conley |
| Isolation Date: | 2009-09-04 |
| Date Received: | 2009-10-19 |
| Characters: | CULTURE CONDITIONS produced oxalic acid crystals - // HUMAN/ ANIMAL PATHOGEN severe pneumonia in Alligator mississippiensis associated with oxalosis - Hall NH, Conley K, Berry C, Farina L, Sigler L, Wellehan JF, Roehrl MHA, Heard D, J Zoo Wild Med (in press) 2011 // MOLECULAR SYSTEMATICS Blast match 99% ITS similarity to Metarhizium anisopliae - fide UAMH 2010 (Click for publications citing UAMH 11138) |
| Compounds: | |
| Cross Reference: | |
| Collections: | Living Strains; Dried Herbarium Material |
| Pathogenic Potential: | Human: yes | Animal: yes | Plant: no |
| Biosafety Risk Group: | RG1 (check the PHAC ePATHogen Risk Group Database for updates) |
| Regulatory Requirements: | No restrictions for Canadian requesters. International requesters must provide all legally required importation documentation prior to shipment. This strain is not available for shipment to Cuba, the Democratic People's Republic of Korea, Iran or Syria. Plant pathogenicity status may be verified by using the USDA Agricultural Research Service (ARS) Fungal Database |
| MycoBank ID: | 101834 |
| Sequences: | >UAMH11138_HQ539658_SSU-LSU TGAACCAGCGGAGGGATCATTACCGAGTTATCCAACTCCCAACCCCTGTGAATTATACCTTTAATTGTTGCTTCGGCGGGACTTCGCGCCCGCCGGGGACCCAAACCTTCTGAATTTTTTAATAAGTATCTTCTGAGTGGTTAAAAAAAATGAATCAAAACTTTCAACAACGGATCTCTTGGTTCTGGCATCGATGAAGAACGCAGCGAAATGCGATAAGTAATGTGAATTGCAGAATTCAGTGAATCATCGAATCTTTGAACGCACATTGCGCCCGTCAGTATTCTGGCGGGCATGCCTGTTCGAGCGTCATTACGCCCCTCAAGTCCCCTGTGGACTTGGTGTTGGGGATCGGCGAGGCTGGTTTTCCAGCACAGCCGTCCCTTAAATTAATTGGCGGTCTCGCCTTGGCCCTCCTCTGCGCAGTAGTAAAACACTCGCAACAGGAGCCCGGCGCGGTCCACTGCCGTAAAACCCCCCAACTTTTTATAGTTGACCTCGAATCAGGTAGGACTACCCG |
IMAGES:






















